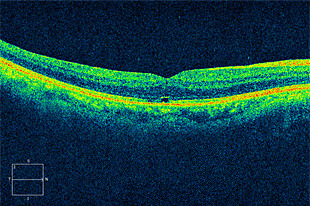
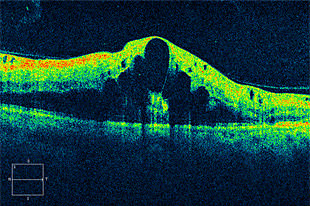

網膜硝子体手術
VITREORETINAL
- 診療のご案内
- 網膜硝子体手術
網膜硝子体手術について

網膜硝子体とは?

眼球の内部には、その内腔の大部分を占める「硝子体」という透明のゼリー状の組織があります。
この組織は網膜に病気が生じると網膜を牽引したり、炎症を持続させたり、混濁や出血を生じたりと、その進行に大きく関わります。
硝子体手術は、この硝子体を切除することで病気の進行を抑え、視力回復を図ります。
近年、技術の進歩により比較的安全に手術ができるようになったこともあり、当院では日帰り硝子体手術を行っております。
この組織は網膜に病気が生じると網膜を牽引したり、炎症を持続させたり、混濁や出血を生じたりと、その進行に大きく関わります。
硝子体手術は、この硝子体を切除することで病気の進行を抑え、視力回復を図ります。
近年、技術の進歩により比較的安全に手術ができるようになったこともあり、当院では日帰り硝子体手術を行っております。
裂孔原性網膜剥離
硝子体の牽引により網膜に裂孔が生じ、網膜下に水(液化硝子体)が入り込むことで網膜剥離が生じます。

術前

術後
糖尿病網膜症
糖尿病が進行すると出血や黄斑部に浮腫(黄斑浮腫)を起こし、視力低下をきたします。
また、さらに進行すると新生血管が出現し、大出血(硝子体出血)や牽引性の網膜剥離をきたします。
また、さらに進行すると新生血管が出現し、大出血(硝子体出血)や牽引性の網膜剥離をきたします。

術前

術後
黄斑円孔
網膜の中心である黄斑部に穴が開く病気で、視野の中央が見えにくくなります。

術前写真

術前 OCT

術後写真
術後 OCT
黄斑前膜
網膜の中心である黄斑上に膜が張り、視力低下や、歪みをきたします。

術前

術後
網膜静脈閉塞症
網膜静脈が詰まり、その先の静脈が拡張して蛇行し、眼底出血や浮腫が起きます。
出血や浮腫が黄斑部にかかると視力低下をきたします。
出血や浮腫が黄斑部にかかると視力低下をきたします。

術前写真
術前 OCT

術後写真

術後 OCT

上記以外にも硝子体手術の適応になる疾患はございます。不明な点は院長にお尋ねください。
疾患によっては術中眼内に充填物(ガス、シリコンオイル)を注入することで、術後数日間のうつ伏せや体位制限が必要になります。
疾患によってはレーザー治療や眼球内への薬剤注射(硝子体内注射)等、他の治療法を併用する場合がございます。
日帰り手術よりも入院治療が望ましいと判断される疾患の場合は、対応可能な施設へ紹介致します。
疾患によっては術中眼内に充填物(ガス、シリコンオイル)を注入することで、術後数日間のうつ伏せや体位制限が必要になります。
疾患によってはレーザー治療や眼球内への薬剤注射(硝子体内注射)等、他の治療法を併用する場合がございます。
日帰り手術よりも入院治療が望ましいと判断される疾患の場合は、対応可能な施設へ紹介致します。
